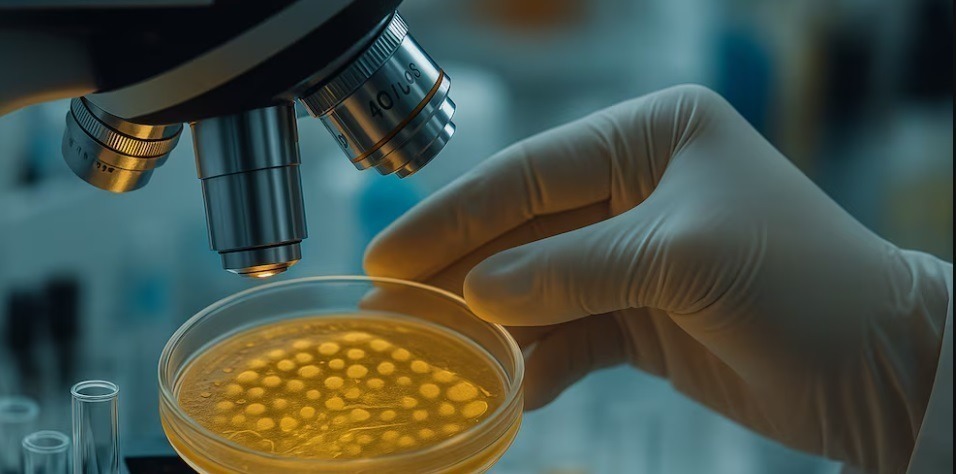

La autoridades sanitarias detectaron bacteria Listeria monocytogenes en un tipo de queso común de pasta blanda. Advierten especialmente el riesgo en personas inmunosuprimidas y mujeres embarazadas
ANMAT advierte por presencia de Listeria monocytogenes en lote de queso Cremón doble crema
La Administración Nacional de Medicamentos, Alimentos y Tecnología Médica (ANMAT) emitió una advertencia dirigida a la población tras la detección de Listeria monocytogenes en un lote específico de queso de pasta blanda Cremón doble crema, marca La Serenísima. Aunque el producto ya se encuentra fuera de su período de aptitud, la autoridad sanitaria subrayó que persiste un riesgo residual para quienes hayan conservado el queso más allá de su fecha de vencimiento, especialmente mediante congelación, lo que podría afectar a personas inmunosuprimidas y mujeres embarazadas.
Fuente: InfoB